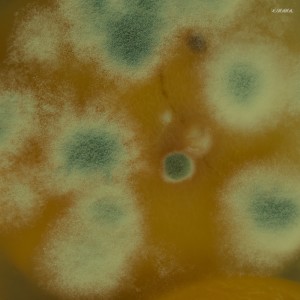
ดาวน์โหลดและฟังเพลง Spark Plug พร้อมเนื้อเพลงจาก The Spectaphiles

ไม่มีข้อมูลเนื้อร้อง
เกี่ยวกับเพลงนี้ :
Spark Plug จาก The Spectaphiles ปล่อยเมื่อวันที่ 1 ก.ย. 2023. ฟังเพลง Spark Plug พร้อมทั้งเนื้อเพลงโดย The Spectaphiles. ดาวน์โหลด JOOX Application เพื่อฟังเพลง Spark Plug และ ดูมิวสิควีดีโอเพลง Spark Plug แบบ online ได้ทันที!
Tags ที่เกี่ยวข้อง :
Spark Plug (โดย The Spectaphiles), Spark Plug, Spark Plug มิวสิควีดีโอ, Spark Plug เนื้อเพลง, The Spectaphiles เพลง